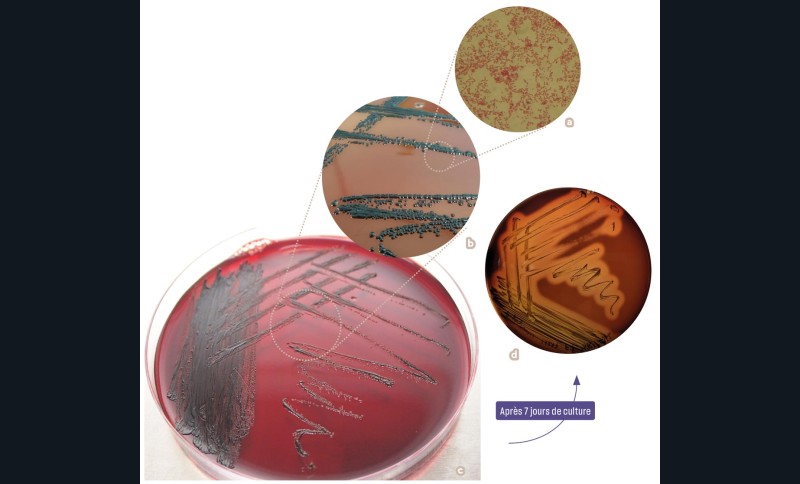

L’objectif de cette rubrique est de rédiger la carte d’identité d’un habitant du parodonte. Elle présente l’identité de l’habitant (procaryote ou eucaryote), son rôle, son habitat et tout autre caractéristique, y compris la pathogénie si elle existe. L’iconographie va du macroscopique au microscopique, voire ultra-microscopique.
Nom • Porphyromonas gingivalis
Date de description • 1988 par Shah et Collins
Parenté • genre Porphyromonas (Genre I) appartient à la famille Porphyromonadaceae (Famille III) de l’ordre Bacteroidales (Ordre I) … du phylum Bacteroidota (Phylum XX) du domaine Bacteria Porphyromonas du gr. porphureos « de couleur pourpre » et du gr. monas « unité »
Synonyme • avant 1980 Bacteroïdes melaninogenicus
Composition • cytoplasme, capsule, hémagglutinine, gingipaïnes
Domicile • cavité buccale de l’être humain
Porphyromonas gingivalis (P. gingivalis) est sans doute, après Streptococcus mutans, la bactérie dont le nom est gravé dans les mémoires de nombreux praticiens chirurgiens-dentistes.
Mais qui est P. gingivalis ?
Description
P. gingivalis est un bacille, ou coccobacille, à Gram négatif (fig. 1a), immobile, encapsulé, non sporulé, anaérobie strict. Pour l’isoler d’un biofilm dentaire, le prélèvement doit être mis en anaérobiose. Sur gélose au sang, les P. gingivalis forment des colonies, d’un diamètre variant de 1 à 2 mm (fig. 1b). Ces colonies sont lisses, brillantes et convexes. Après 4 à 8 jours de culture, elles se pigmentent progressivement en brun foncé ou noir (fig. 1c), et une hémolyse est présente (fig. 1d). La bactérie est de petite taille (0,5 à 1 µm de diamètre pour une longueur de 2 µm). Elle peut être visualisée en microscopie con- focale (fig. 2a), en microscopie électronique en transmission (fig. 2b) et en microscopie électronique à balayage (fig. 2c).
Croissance
La croissance de…